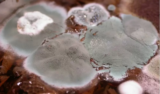

Significado de sonhar com lugares
Sonhar com mofo, de modo geral, é o prenúncio de dificuldades e obstáculos que podem afetar a sua vida como um todo. Porém, cabe a você agir de forma prática ...
Sonhar com laje caindo demonstra que algo está acontecendo e que não adianta lutar contra esse fato. Por isso, é importante cultivar a aceitação de que ...
O conhecimento pode ser adquirido em qualquer lugar, inclusive nos ambientes sagrados. Porém, apesar dessa afirmação, existem pessoas que possuem resistências ...
O corredor simboliza o caminho trilhado para chegar a algum lugar, um objetivo. Por isso, quando aparece em sonhos, o corredor pode falar sobre escolhas, ...
Sonhar com demolição não é algo tão inesperado, pois em geral muitas pessoas acabam por ver durante seu sono situações que causam medo ou algum espanto. Esse ...
As paredes são fundamentais para manter uma casa de pé. Porém, quando uma delas caem, ainda sim é possível consertar. Desse modo, quando em sonho uma parede ...
Se você está aqui, provavelmente sonhou com vazamento de água, nos últimos dias. Buscar entender os sonhos é de suma importância, para que se fique atento aos ...
Sonhar com um telhado traz muitas revelações, principalmente as que estão ligadas aos aspectos emocionais, trazendo possibilidades do sentimento de proteção ...
Os sonhos trazem mensagens particulares e que revelam aspectos da vida do sonhador que merecem mais atenção e que passam despercebidos por estes. Sonhar com ...
O sonho com medo de altura é um sinal de que você tem sido dominado pelas suas emoções. Isso significa que, agora, é necessário olhar para os problemas com ...
Sonhar com muro traz avisos importantes para os sonhadores, estes presságios falam sobre um sentimento comum entre as pessoas que tem esta visão. Isso, pois ...
Sonhar com prédio abrange uma infinidade de significados relacionados principalmente ao sucesso profissional e aos desejos de conquista de quem sonha. O ...
- 1
- 2
- 3
- …
- 15
- Próxima página »
Signficado de sonhar com lugares